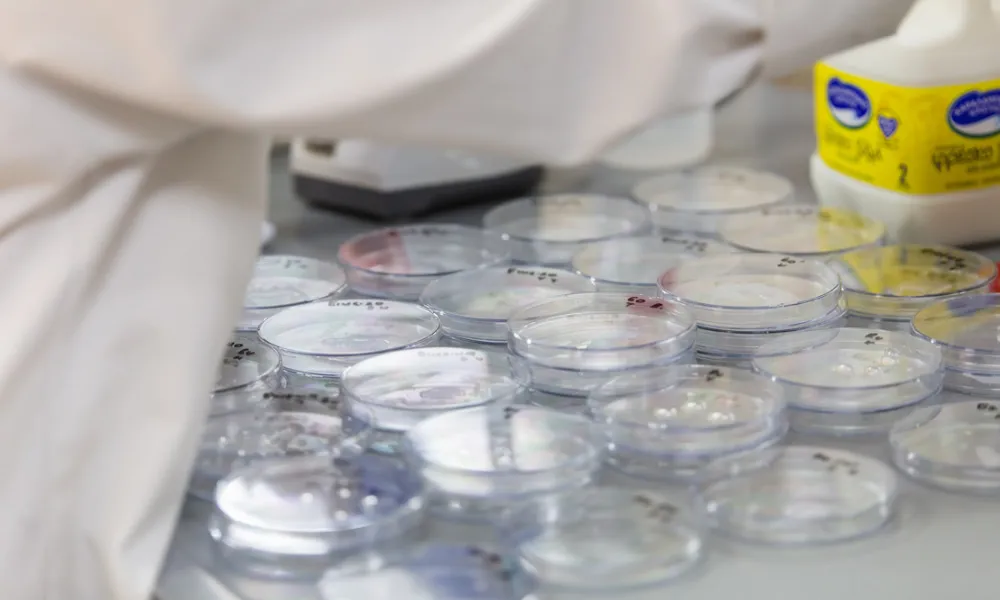
Header Image

Το Animal Welfare προάγει μια πιο ηθική προσέγγιση στην παραγωγή γάλακτος και ενδυναμώνει τη σχέση εμπιστοσύνης με τον καταναλωτή
Σε μια περίοδο σοβαρών προκλήσεων για τον τομέα της κτηνοτροφίας και την κυπριακή γαλακτοβιομηχανία, η εταιρεία Χαραλαμπίδης Κρίστης συνεχίζει να επενδύει σταθερά στην ποιότητα και την καινοτομία, ενισχύοντας τις υποδομές της, εφαρμόζοντας κορυφαία διεθνή πρότυπα και προωθώντας την ανάπτυξη του ανθρώπινου δυναμικού της.
Ο Διευθύνων Σύμβουλος, Μάριος Κωνσταντίνου, σε συνέντευξή του στον «Π» αποτυπώνει τις τάσεις της αγοράς και αναφέρεται στις επιπτώσεις της κρίσης του αφθώδους πυρετού. Τονίζει, μεταξύ άλλων, την ανάγκη για συλλογική και συντονισμένη προσπάθεια με στόχο την πλήρη αναχαίτιση της επιδημίας, τη σταδιακή αναπλήρωση του απολεσθέντος ζωικού κεφαλαίου και γάλακτος, καθώς και τη διατήρηση της δυναμικής του κυπριακού χαλλουμιού στις διεθνείς αγορές.
Επιπρόσθετα, αναφέρεται στις βιώσιμες πρακτικές και την περιβαλλοντική πολιτική που εφαρμόζει η εταιρεία, επισημαίνοντας ότι η προσήλωση στην ποιότητα συμβάλλει καθοριστικά στη διατήρηση της εμπιστοσύνης των καταναλωτών.
Με δεδομένες τις προκλήσεις που αντιμετωπίζει ο κλάδος, σε ποιους άξονες εστιάζει το πλάνο της εταιρείας για τη θωράκιση της παραγωγής;
Ανεξαρτήτως της τρέχουσας κρίσης του αφθώδους πυρετού, ως εταιρεία εστιάζουμε διαρκώς στη βελτίωση των συνθηκών διαβίωσης των ζώων, μέσα και από την εφαρμογή κορυφαίων διεθνών προτύπων, ώστε να προσφέρουμε την καλύτερη δυνατή ποιότητα στα γαλακτοκομικά προϊόντα που παράγουμε. Παράλληλα, εκσυγχρονίζουμε διαρκώς τις υποδομές μας και τον εξοπλισμό της γραμμής παραγωγής, με πιο πρόσφατη την αναβάθμιση της γραμμής γάλακτος. Πρωτίστως, εστιάζουμε στη δύναμη της ομάδας μας, επενδύοντας στη διαρκή εκπαίδευση και εξέλιξη των ανθρώπων που αποτελούν τη Χαραλαμπίδης Κρίστης, στην καλλιέργεια κουλτούρας σεβασμού και στην ενθάρρυνση ανάληψης πρωτοβουλιών. Πιστεύουμε ότι αυτή η κουλτούρα ενθαρρύνει την καινοτομία και δημιουργεί έναν οργανισμό που εξελίσσεται συλλογικά.

Η Χαραλαμπίδης Κρίστης έχει υιοθετήσει διεθνή πρότυπα όπως το Animal Welfare. Ποιο είναι το όφελος για τον καταναλωτή;
Το Animal Welfare είναι ένα κορυφαίο διεθνές πρότυπο ποιότητας στη γαλακτοβιομηχανία, το οποίο διασφαλίζει την υγεία, την ευζωία και τη σωστή μεταχείριση των ζώων σε όλα τα στάδια της παραγωγής. Το πρότυπο εφαρμόζεται πλέον στο δίκτυο συνεργαζόμενων φαρμών μας, προάγοντας βιώσιμες πρακτικές που μειώνουν το στρες των ζώων και ενισχύουν την παραγωγικότητα. Ως αποτέλεσμα, βελτιώνεται η ποιότητα του γάλακτος και των παραγόμενων προϊόντων, ενώ ταυτόχρονα προάγεται μια πιο ηθική προσέγγιση στην παραγωγή, ενδυναμώνοντας τη σχέση εμπιστοσύνης με τον καταναλωτή.
Ωστόσο, ο κλάδος της γαλακτοβιομηχανίας δοκιμάζεται έντονα λόγω του αφθώδους πυρετού. Ποια είναι η εκτίμησή σας για την πορεία της αγοράς τους επόμενους μήνες;
Η επιδημία του αφθώδους πυρετού αποτελεί μια σημαντική πρόκληση για την ευρύτερη αλυσίδα της κτηνοτροφίας και της γαλακτοβιομηχανίας. Ως εταιρεία παρακολουθούμε στενά τις εξελίξεις και βρισκόμαστε σε συνεχή επαφή και συνεργασία με τις αρμόδιες κρατικές υπηρεσίες, συμβάλλοντας ενεργά στη διαχείριση της δύσκολης αυτής κατάστασης.
Κρούσματα συνεχίζουν να εμφανίζονται, όμως πιστεύουμε πως με την υλοποίηση των μαζικών εμβολιασμών και εφόσον τηρηθούν τα αυστηρά μέτρα βιοασφάλειας σε όλη την εφοδιαστική αλυσίδα του κλάδου, η επιδημία μπορεί να ανακοπεί. Η αγορά επιδεικνύει σημαντική ανθεκτικότητα, απορροφώντας τις πιέσεις της περιόδου. Η παραγωγή χαλλουμιού παραμένει υπό έλεγχο, ενώ η διαθεσιμότητα γάλακτος πιέζεται καθώς οι απώλειες γάλακτος υπολογίζονται στο 3% της συνολικής διαθέσιμης ποσότητας. Είναι θετικό το γεγονός ότι παρά την κρίση, καμία χώρα δεν έχει θέσει περιορισμούς στις εξαγωγές χαλλουμιού, το οποίο αποτελεί κύριο εξαγωγικό προϊόν με κομβικό ρόλο για την κυπριακή οικονομία.
Με συνετή διαχείριση, υπάρχει η δυνατότητα τους επόμενους μήνες, εφόσον εφαρμοστούν πλήρως τα αναγκαία μέτρα, να καλυφθούν οι απώλειες και να επανέλθει η ομαλότητα. Ωστόσο, είναι κρίσιμο να υπάρξει πλήρης έλεγχος και να αποφευχθεί οποιοδήποτε πισωγύρισμα, με νέα κρούσματα ή επέκταση της κρίσης σε νέες περιοχές.
Ενίσχυση ελέγχων και πάταξη λαθρεμπορίου
Ως Πρόεδρος του Συνδέσμου Τυροκόμων, πώς αποτιμάτε μέχρι στιγμής τις απώλειες και ποια είναι η μεγαλύτερη πρόκληση που αντιμετωπίζουν οι παραγωγοί;
Η άμεση πρόκληση για το σύνολο του κλάδου είναι η πλήρης αναχαίτιση της επιδημίας, ώστε στη συνέχεια να εστιάσουμε τις προσπάθειές μας στη σταδιακή αναπλήρωση του απολεσθέντος ζωικού κεφαλαίου και γάλακτος. Η διαδικασία αυτή απαιτεί χρόνο, συνέπεια και συντονισμένη προσπάθεια, προκειμένου να επανέλθουμε στα επίπεδα παραγωγής γάλακτος που υπήρχαν πριν από την εμφάνιση των κρουσμάτων.
Μέχρι σήμερα οι απώλειες ανέρχονται περίπου στο 6% του αιγοπρόβειου πληθυσμού, ο οποίος βάσει της ποσόστωσης συμβάλλει κατά περίπου 20% στην παραγωγή γάλακτος για χαλλούμι. Πρόκειται για σημαντική μείωση, ωστόσο, η αγορά συνεχίζει να λειτουργεί ομαλά, καθώς η παραγωγή και διάθεση χαλλουμιού παραμένουν υπό έλεγχο, εν μέρει και λόγω των διαθέσιμων αποθεμάτων.
Εφόσον τα κρούσματα αφθώδους πυρετού ελεγχθούν πλήρως, τότε το βασικό στοίχημα για τους επόμενους μήνες θα είναι η ικανότητα της παραγωγής να ανταποκριθεί στην υψηλή ζήτηση για χαλλούμι. Είναι γεγονός ότι η κρίση ήρθε ακριβώς τη στιγμή που το χαλλούμι είχε αναπτύξει μια πολύ καλή δυναμική -σημειώνοντας μάλιστα ρεκόρ πέρσι στις εξαγωγές- και χρειάζεται όλοι οι παραγωγοί να παλέψουμε για να μην αναχαιτιστεί αυτή η πορεία.
Η δημιουργία της Ειδικής Επιστημονικής Επιτροπής για την ανασυγκρότηση και αναβάθμιση του κτηνοτροφικού τομέα της χώρας αποτελεί ευκαιρία να εξέλθει ο κλάδος πιο δυνατός από την κρίση και να θωρακιστεί για τις προκλήσεις του μέλλοντος. Ως Σύνδεσμος έχουμε καταθέσει εισηγήσεις, αρκετές από τις οποίες ήδη εφαρμόζονται.
Είναι ιδιαίτερα σημαντικό να ενισχυθούν οι έλεγχοι σε όλο το μήκος της νεκρής ζώνης για την πάταξη του λαθρεμπορίου καθώς και η βελτίωση του ελέγχου των μονάδων σε γκρίζες περιοχές όπως αυτή στο Πέργαμος. Σε μεταγενέστερο στάδιο, ενδεχομένως να επανεξεταστεί και το ζήτημα της ποσόστωσης, λόγω της απώλειας αιγοπροβάτων και της μικρότερης παραγωγικής τους δυνατότητας σε σύγκριση με τα βοοειδή. Ωστόσο, αυτή τη στιγμή, η προσοχή όλων είναι στραμμένη στον τερματισμό της κρίσης, τη συγκράτηση των απωλειών και την ταχύτερη δυνατή αναπλήρωση του ζωικού κεφαλαίου.
Προϊόντα υψηλής διατροφικής αξίας
Υπάρχει χώρος για καινοτομία στην αγορά των γαλακτοκομικών; Πώς διαμορφώνονται οι τάσεις στους καταναλωτές;
Οι καταναλωτικές τάσεις είναι διαρκώς μεταβαλλόμενες, καθώς ολοένα και περισσότεροι καταναλωτές στρέφονται σε ποιοτικά, υγιεινά, πρωτεϊνούχα και λειτουργικά γαλακτοκομικά προϊόντα. Παρατηρείται αυξανόμενο ενδιαφέρον για προϊόντα υψηλής διατροφικής αξίας, εναλλακτικές επιλογές όπως τα delact καθώς και νέες φυτικές επιλογές, που δημιουργούν σημαντικά περιθώρια καινοτομίας. Παράλληλα, τα παραδοσιακά προϊόντα διατηρούν τη δυναμική τους, με τα τυροκομικά και το γάλα να παραμένουν στις κορυφαίες επιλογές των καταναλωτών.
Πέραν του τελικού προϊόντος, ως κλάδος καλούμαστε να ανταποκριθούμε στις αυξανόμενες περιβαλλοντικές προκλήσεις, με κυριότερες την καλή διαβίωση των ζώων, αλλά και την κλιματική αλλαγή, που απαιτεί βιώσιμες πρακτικές σε όλη την αλυσίδα παραγωγής. Στο πλαίσιο αυτό επενδύουμε σε πιο φιλικές προς το περιβάλλον λύσεις που αφορούν τις συσκευασίες, τις εγκαταστάσεις μας και τη μείωση της σπατάλης, βελτιώνοντας διαρκώς το συνολικό περιβαλλοντικό μας αποτύπωμα.
Με ποιους τρόπους επενδύετε στην Χαραλαμπίδης Κρίστης στον τομέα της ποιότητας;
Ως η μεγαλύτερη και μακροβιότερη κυπριακή γαλακτοβιομηχανία, με περισσότερες από οχτώ δεκαετίες παρουσίας στον χώρο, έχουμε επενδύσει πέραν των 20 εκατομμυρίων ευρώ για την ανανέωση και τον εκσυγχρονισμό των μηχανολογικών εγκαταστάσεων του εργοστασίου μας.
Παράλληλα, εφαρμόζουμε τα κορυφαία διεθνή πρότυπα ποιότητας και τεχνογνωσίας, προκειμένου να προσφέρουμε προϊόντα υψηλής διατροφικής αξίας. Ανάμεσά τους ξεχωρίζουν η διαπίστευση CYS EN ISO/IEC 17025:2017 στο Εργαστήριο Ποιοτικού Ελέγχου στη Λεμεσό για τον αυτοέλεγχο του νωπού γάλακτος και το AIΒ International, ένα από τα πιο αναγνωρισμένα πρότυπα παγκοσμίως στον τομέα της ασφάλειας και ποιότητας τροφίμων, το οποίο επιβεβαιώνει τη συμμόρφωση της Χαραλαμπίδης Κρίστης με αυστηρές διαδικασίες ελέγχου, την ορθή βιομηχανική πρακτική και τις προδιαγραφές ασφάλειας τροφίμων σε όλα τα στάδια παραγωγής.
Χάρη στην εξασφάλιση και συνεχή ανανέωση των διεθνών προτύπων, η εταιρεία μας διαθέτει ισχυρή εξαγωγική παρουσία σε 37 χώρες, ενώ μας εμπιστεύονται μερικές από τις κορυφαίες πολυεθνικές για τη διανομή των προϊόντων τους στην Κύπρο. Με αυτό τον τρόπο μετουσιώνουμε σε πράξη το σύνθημα «το καλύτερό μας», που διαπνέει την εταιρική μας κουλτούρα σε κάθε στάδιο της παραγωγής.